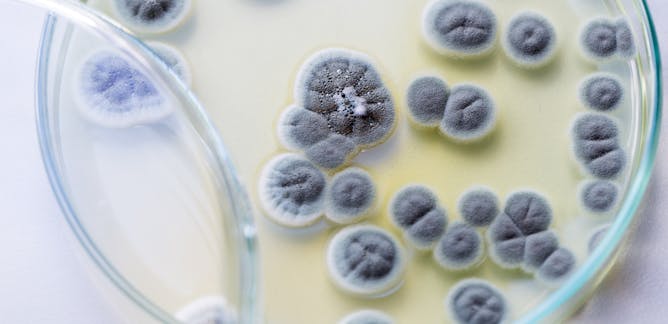

Saint Valentine is the patron saint of love and this fourth most common neurological disorder which affects people of all ages.
Epilepsy
In South Korea what do youth do if they do not receive a single Valentine?
Go to a cafe and eat black noodles to mourn their single status on "Black Day" April 14th.
Nationally, a box of chocolates is the most sold candy on Valentine's Day. What's the second?

In which play of William Shakespeare's does he mention Valentine's Day?
Hamlet
In the Middle Ages, young men and women drew names to see who their Valentine would be. They would wear the name pinned to their sleeve for one week so that everyone would know their supposed true feelings, thus giving us what modern day phrase?
Wearing your heart on your sleeve.
Which Union general who fought in the American Civil War and is famous for his battles through the South, died on February 14, 1891?
William Tecumseh Sherman
Marylanders ironically enjoy these M stamped candies the most though, as they are the top state sellers.

What does the Latin word 'Valentinus' mean?
strong, powerful, worthy
What Italian city receives over 1000 Valentine's usually addressed to these star-crossed lovers each year?
Verona, from Romeo and Juliet
According to the National Confectioners Association, __________ are the most popular flavor in chocolate boxes.
Caramels, followed by chocolate-covered nuts, chocolate-filled, cream-filled, and coconut.
How would young men and women in the Middle Ages determine who their Valentine would be?
They would draw names from a bowl.
James Knox Polk, is famous for being the first president to ______________ on February 14, 1849. (Smile!)
Be Photographed
Who created the first candy box and who's company still produces worldwide?
Richard Cadbury created them in 1868
Get your helmet and your smokepot- he's also the patron saint for these sweet workers.
Beekeepers
You won't find the Welsh celebrating Saint Valentine -- instead, people in Wales celebrate Saint Dwynwen, the Welsh patron saint of lovers, on January 25th. Serve up some love with this traditional, carved gift.
A love spoon
What pre-Roman festival does Valentine's Day fall during (and is perhaps a VERY toned down offshoot of)?
Lupercalia was an ancient, pastoral annual festival, observed in the city of Rome from the 13th to the 15th of February to avert evil spirits and purify the city, releasing health and fertility.
Sir Alexander Fleming discovers this after leaving a plate of staphylococcus bacteria uncovered on this day in 1929.
Penicillin
Both men and women prefer to receive chocolate over flowers, according to the National Confectioners Association. The survey also found that chocolate sales represent what percent or more of Valentine's Day candy purchases?
90% 85% or 75%
75%